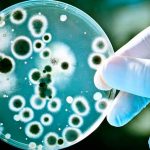
Descubren bacteria causante del Alzheimer salud

Etiqueta: bacteria
Supervisan avances en construcción de laboratorio clínico en Jinotepe
En un 90% se encuentran los avances de la construcción del Laboratorio Clínico del Hospital Regional Santiago de Jinotepe, así lo constató tras una...
No te dejes lamer por tu mascota si tienes heridas, !puede ser mortal!
Un hombre de 63 años, que hasta entonces se encontraba en buen estado de salud, murió al contraer una rara infección ocasionada por una...
Modelo fallece tras comer hamburguesa con ingredientes descompuestos
El modelo Israel Boucher, quien representó a Perú en el concurso Mister Universo en 2016, falleció recientemente a los 22 años en un centro...
Fallece un estadounidense tras perder el 25% de su piel por una bacteria
David Ireland, exmarine de 50 años y padre de dos niñas, que padecía una grave infección por una bacteria carnívora, no logró vencer a...
Le amputan brazos y piernas luego que su perro le lamiera una herida
El caso de Marie Trainer ha preocupado a miles de personas. La mujer originaria de Estados Unidos creyó que había contraído un simple resfriado...
Mueren 11 bebés en un hospital por una infección bacteriana en Kenia
Once bebés murieron la semana pasada en la unidad de recién nacidos del Nacional Kenyatta (KNH) en Nairobi, el hospital público más grande de...
Descubren bacteria que se come la contaminación y genera electricidad
Un equipo de científicos liderado por Abdelrhman Mohamed, de la Universidad Estatal de Washington, ha logrado capturar por primera vez una inusual bacteria que...
Nuevos datos reveladores sobre el origen del cáncer
El cáncer requiere de múltiples cambios en las propiedades celulares, y la acumulación de las mutaciones que producen estos cambios se puede acelerar.
Un estudio...
Esta bacteria se aloja en tu boca y luego ataca tu corazón
Una bacteria que se aloja en la boca puede producir problemas circulatorios y hacer que se bloquee el paso de la sangre hasta el...